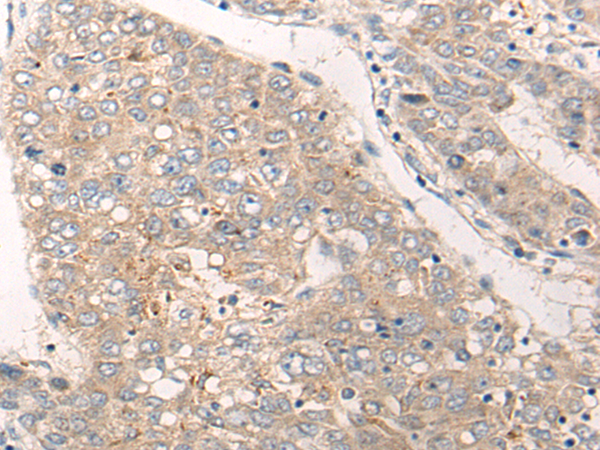
一抗

中文名稱: 兔抗SLC9A3R1多克隆抗體
英文名稱: Anti-SLC9A3R1 rabbit polyclonal antibody
別 名: EBP50; NHERF; NHERF1; NHERF-1; NPHLOP2
抗 原: SLC9A3R1
儲(chǔ) 存: 冷凍(-20℃)
宿 主: Rabbit
反應(yīng)種屬: Human, Mouse, Rat
相關(guān)類別: 一抗
標(biāo) 記 物: Unconjugate
克隆類型: rabbit polyclonal
|
Background: |
This gene encodes a sodium/hydrogen exchanger regulatory cofactor. The protein interacts with and regulates various proteins including the cystic fibrosis transmembrane conductance regulator and G-protein coupled receptors such as the beta2-adrenergic receptor and the parathyroid hormone 1 receptor. The protein also interacts with proteins that function as linkers between integral membrane and cytoskeletal proteins. The protein localizes to actin-rich structures including membrane ruffles, microvilli, and filopodia. Mutations in this gene result in hypophosphatemic nephrolithiasis/osteoporosis type 2, and loss of heterozygosity of this gene is implicated in breast cancer. |
|
Applications: |
ELISA, IHC |
|
Name of antibody: |
SLC9A3R1 |
|
Immunogen: |
Synthetic peptide of human SLC9A3R1 |
|
Full name: |
SLC9A3 regulator 1 |
|
Synonyms: |
EBP50; NHERF; NHERF1; NHERF-1; NPHLOP2 |
|
SwissProt: |
O14745 |
|
ELISA Recommended dilution: |
5000-10000 |
|
IHC positive control: |
Human liver cancer |
|
IHC Recommend dilution: |
20-100 |

 購(gòu)物車
購(gòu)物車 幫助
幫助
 021-54845833/15800441009
021-54845833/15800441009